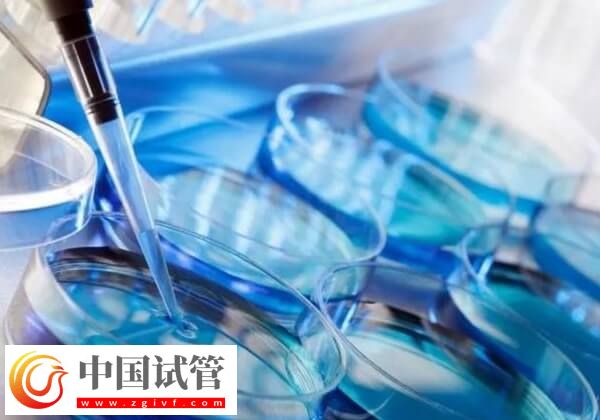
怎样提高胚胎移植着床率(图1)

做试管婴儿治疗的患者,若是想要提高胚胎着床率,那么可以从均衡饮食营养、保证充足的睡眠和适当的活动等多个方面进行调节和优化,这样可以为胚胎的着床和发育提供营养支持,从而提高胚胎的着床率。其次移植后严格遵医嘱使用黄体支持药物,对维持内膜的稳定也是非常重要的。
提高胚胎移植着床率的方法
对于我国现在的试管婴儿技术而言,不能保证多有人都一次成功,因此就有一些移植后的秘方帮助提高试管婴儿的成功率,如果大家想要了解,提高胚胎移植着床率的方法都包括哪些,可参考下列内容:
1、饮食调理
胚胎移植之后,女性一定要多吃一些富含蛋白质的食物,为身体及时补充蛋白质,蛋白质不仅可以让女性的身体机能尽快恢复,还能提高免疫力,为胚胎发育提供所需营养,这些都是胚胎着床的重要条件。
2、卧床休息
女性在胚胎移植后的第二天,一定要卧床休息,休息时以平躺为最佳,如果需要起床的话,动作不能过快过猛,要尽量将动作放轻放缓,这样是为了胚胎更稳定的在宫内着床和发育。
3、药物支持
在试管移植之后,患者还需要服用一些黄体药物,如黄体酮,以维持子宫内膜的稳定,这样能够提高胚胎的着床几率,所以在试管移植后,建议患者严格遵医嘱使用相关药物。

4、情绪调节
保持心情愉悦是提高胚胎移植着床率的方法,一般建议患者胚胎移植后,要注意避免过度紧张和焦虑。毕竟情绪的波动会影响身体的内分泌系统,进而影响胚胎着床。
5、定期复查
在试管婴儿移植后,若是想要提高胚胎的着床几率,那么患者还要按照医生的安排进行血hCG检测、孕酮测定及超声检查等,密切关注胚胎着床及发育情况。





